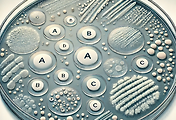

Acinetobacter baumannii는 다제내성균(MDR, Multidrug-resistant pathogen)의 대표적인 예로, 항생제 저항성에 대한 기전이 매우 복잡하고 다면적입니다. 특히 IRAB (Imipenem-resistant *Acinetobacter baumannii)는 병원 내 감염에서 특히 심각한 문제로 대두되고 있으며, 치료에 사용 가능한 항생제 옵션이 매우 제한적입니다. IRAB의 내성 기전은 여러 생화학적 과정과 유전적 변형을 통해 발생하며, 이를 이해하는 것이 감염 관리와 새로운 치료법 개발에 매우 중요합니다.
IRAB의 주요 내성 기전
1. 카바페넴 분해 효소 생성 (Carbapenemase production)
IRAB의 가장 흔한 내성 기전 중 하나는 카바페넴 분해 효소(Carbapenemase)를 생성하는 것입니다.
이 효소는 항생제의 β-락탐 구조를 파괴하여 항생제의 효과를 무력화시킵니다. 특히 OXA-23, OXA-24, OXA-58과 같은 OXA형 β-락타마제는 전 세계적으로 확산된 IRAB에서 발견되며, 이러한 효소는 주로 플라스미드와 같은 이동성 유전자를 통해 세균 간에 확산됩니다. 카바페넴 분해 효소는 세균이 항생제를 분해하는 주된 방법으로, 이는 카바페넴 계열 항생제인 이미페넴을 포함한 여러 항생제에 저항성을 부여합니다.
2. 유전자 돌연변이 (Genetic mutations)
IRAB는 gyrA와 parC 같은 유전자에 돌연변이를 일으켜 퀴놀론계 항생제에 대한 내성을 유발합니다.
DNA gyrase와 Topoisomerase IV는 세균의 DNA 복제에 중요한 효소로, 이 효소들이 항생제에 결합하는 부위에 돌연변이가 발생하면 항생제의 결합이 방해받아 효과를 발휘하지 못합니다
이러한 돌연변이들은 주로 퀴놀론계 항생제에 대한 내성을 초래하지만, 다른 항생제에 대해서도 교차 내성을 형성할 수 있습니다.
3. Efflux pumps
IRAB는 세균 세포 내부의 약물을 외부로 배출하는 배출 펌프(Efflux pump) 시스템을 과발현시킴으로써 항생제에 대한 저항성을 강화합니다. RND (Resistance-Nodulation-Division) 계열의 배출 펌프 시스템은 다양한 항생제를 세포 외부로 내보내며, 이를 통해 세균 세포 내부로 항생제가 충분히 축적되지 못하도록 합니다. 이 시스템은 아미노글리코사이드, 테트라사이클린, 퀴놀론 등을 포함한 여러 항생제에 대한 내성에 기여합니다
4.막 투과성 변화 (Alteration in membrane permeability)
세균의 외막 단백질(Outer membrane protein, OMP)의 변화도 중요한 내성 기전입니다. 특히 카바페넴 연관 외막 단백질(Carbapenem-associated outer membrane protein, CarO)의 돌연변이나 결손은 세균이 외부 항생제를 흡수하는 능력을 감소시킵니다. 이러한 외막 단백질의 변화는 항생제 투과성을 제한하고, 항생제가 세균 내로 들어오지 못하게 함으로써 내성을 증가시킵니다
IRAB 감염은 주로 중환자실에서 면역이 약한 환자들에게 발생하며
미국 CDC는 CRAB (Carbapenem-resistant A. baumannii)를 "긴급 공중 보건 위협"으로 지정하였으며, IRAB 감염의 치료는 제한적인 항생제 옵션으로 인해 매우 어렵습니다. 폴리믹신 B, 콜리스틴, 테트라사이클린 등의 항생제 조합이 사용되지만, 이들 항생제 역시 내성을 보이는 사례가 보고되고 있습니다
항생제 복합 요법 (Combination therapy)
단일 항생제로 IRAB를 치료하는 것은 효과적이지 않은 경우가 많아, 여러 항생제를 복합적으로 사용하는 치료가 권장됩니다. 폴리믹신 B와 리팜핀의 병용 요법, 또는 테트라사이클린과 카바페넴의 조합 등이 연구되고 있으며, 일부 성공 사례가 보고되고 있습니다
Frontiers | Acinetobacter baumannii in the critically ill: complex infections get complicated
Acinetobacter baumannii is increasingly associated with various epidemics, representing a serious concern due to the broad level of antimicrobial resistance ...
www.frontiersin.org
Portrait of a killer: Uncovering resistance mechanisms and global spread of Acinetobacter baumannii
Antibiotic resistance is a growing global concern in the field of medicine as it renders bacterial infections difficult to treat and often more severe. Acinetobacter baumannii is a gram-negative bacterial pathogen causing a wide range of infections, includ
journals.plos.org

'진단검사의학과 > 미생물학' 카테고리의 다른 글
| 2)CLSI - M100 항균제 감수성 시험 지침 Staphylococcus spp (1) | 2024.08.31 |
|---|---|
| 1)CLSI - M100 항균제 감수성 시험 지침 Enterococcus spp (1) | 2024.08.30 |
| Basic Blood culture : CLSI 권장 Part.1 (0) | 2024.07.28 |
| 살균항생제와 정균항생제 (0) | 2023.07.14 |
| 치약과 구강 : 대표적인 충치균 Streptococcus mutans (0) | 2023.06.17 |
| 비둘기와 공중 보건 위협 - 뇌수막염 Cryptococcus Neoformans (0) | 2023.06.16 |
| Cryptococcus neoformans Test 미생물학 진균학 - 진단검사의학 (2) | 2023.06.16 |
| 콜로니 형성 단위(CFU) 계산 분석 : 미생물검사 2 (0) | 2023.05.30 |

댓글